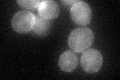
YML016C
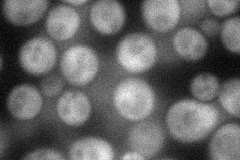
YML016C
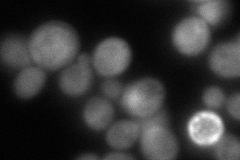
YML016C
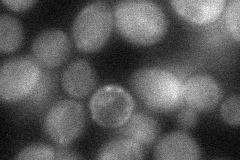
YML016C

View description
Serine/threonine protein phosphatase Z, isoform of Ppz2p; involved in regulation of potassium transport, which affects osmotic stability, cell cycle progression, and halotolerance
Localization:
Intensity:
Fold change:
Significance:
-
C’ GFP library in SD
cell periphery42.4 -
N' NOP1pr-GFP in SD
cytosol48.8886 -
N' TEF2pr-mCherry in SD
cytosol111.279 -
N' NATIVEpr-GFP in SD

cytosol35.635 -
N' TEF2pr-VC and Cyto-VN in SD
cytosol37.6985 -
C’ GFP library in SD+DTT

cell periphery52.671.24No -
C’ GFP library in SD+H2O2

cell periphery49.221.16No -
C’ GFP library in Starvation Media

cell periphery29.750.7No -
C’ GFP library on the background of Pup2-DaMP

cell periphery -
C’ GFP library on the background of CCT mutant

cell periphery41.74810.984513No
